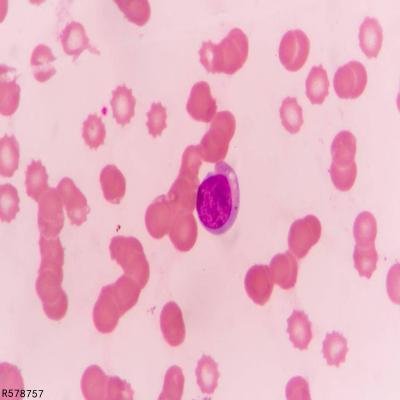
淋巴细胞百分比偏高是什么原因

淋巴细胞百分比偏高容易导致机体免疫系统受损,增加病菌感染风险,危害健康。
要想避免此情况发生,就要格外重视淋巴细胞百分比偏高,根据其诱因做好科学医治,控制病情,减少危害,保障个人健康。
那么,淋巴细胞百分比偏高究竟是怎么回事呢?具体详细介绍如下。
一、病毒感染
淋巴细胞百分比偏高的常见诱因就是病毒感染,如麻疹病毒感染、风疹病毒感染、水痘病毒感染以及流行性腮腺炎病毒感染等,都有可能侵害损伤血液系统,导致患者出现淋巴细胞百分比偏高的症状,危害健康。
二、传染性单核细胞增多症
传染性单核细胞增多症症状表现明显,常见的主要有发热、淋巴结肿大以及肝脾肿大、淋巴细胞百分比偏高、外周血淋巴细胞比例升高等。
三、流行性出血热
淋巴细胞百分比偏高也要考虑为流行性出血热所致,因为流行性出血热反复发作也会刺激损伤机体血液系统,导致患者出现淋巴细胞百分比偏高、中性粒细胞减少等异常症状。
四、化脓性扁桃体炎
化脓性扁桃体炎的典型症状是咽痛、扁桃体肿胀等。
如果这些症状出现后没有及时医治,可能会导致病情加重,出现累及症状,常见的主要有淋巴细胞百分比偏高、反射性耳痛、言语含混不清等。
五、大叶性肺炎
大叶性肺炎多由肺炎链球菌感染所致,发作后主要表现为高热、咳嗽、咳痰、呼吸窘迫、呼吸困难以及淋巴细胞百分比偏高等。
六、淋巴细胞白血病
淋巴细胞白血病反复发作也会刺激损伤血液系统,导致患者出现各种不适病症,常见的主要有发热、出血、感染、各脏器功能障碍以及淋巴细胞百分比偏高等。
淋巴细胞百分比偏高对人体健康影响很大,只要此异常症状发生,就要根据其诱因选择最佳的方法进行医治,缓解不适。
另外,淋巴细胞百分比偏高恢复后,还要注意根据上述所介绍的原因进行科学预防,避免病症再次出现,危害健康,影响恢复。
